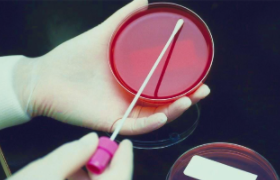

我们在现实生活中有时会遇到因不同原因导致的需要我们和孩子去做一个dna亲子鉴定的情况,大部分人可能并不熟悉期间的流程,因为我们对于...
查看详情 >>
很多网友咨询“因为个人原因想去给腹中胎儿做个dna亲子鉴定,但是该怎么做,这种鉴定可靠吗安全吗?还有需要准备的东西多吗?”,从这些网友的...
查看详情 >>
dna鉴定的方式有很多相信大多数人都有所常识,但是对于尚未出生的胎儿来说如何做胎儿dna鉴定或许大多数人都不太清楚了。其实随着技术的发展这项鉴定也已经能够正...
查看详情 >>
香港作为一个国际的金融中心,除了有些繁华的金融贸易,同时还有着一个让大家非常认可的东西,那便是其医疗水平。了解其基因遗传方面是否隐...
查看详情 >>
DNA大家都有听说过,这是每个人体内都存在的一种物质,同时它也有着非常重要的作用,他决定着一个人的遗传物质以及基因的强弱。因为其具有遗...
查看详情 >>